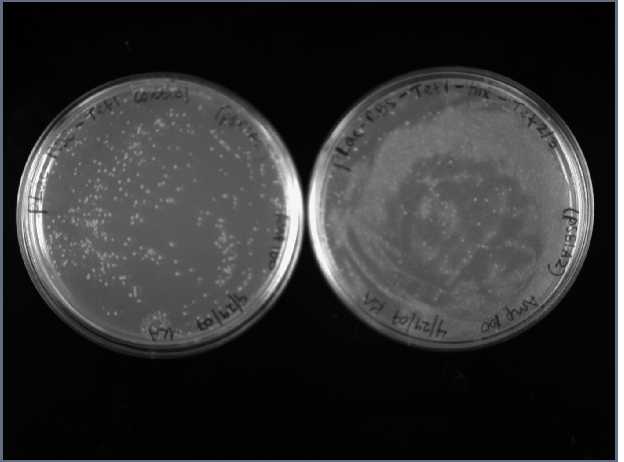

This web page was produced as an assignment for an undergraduate course at Davidson College.
Splitting the Tet-resistance gene, TetA(C)
Where to insert HixC sites?
Since there is no literature documenting attempts to split TetA(C), I had to choose where to insert HixC sites based solely on the TetA(C) protein structure. The TetA(C) gene codes for a tetracycline antiporter that forms a pore in the inner membrane and exports one tetracycline molecule for every proton imported. The intermembrane domain (circled in green below) is a necessary domain for TetA(C) function. Thus, I chose to insert HixC sites in locations that would most likely not interfere with the intermembrane function. I inserted a HixC site between transmembrane domains 1 and 2, and between domains 9 and 10.

Three Tet constructs
My goal was to build a Tet construct with two HixC sites, but first I determined whether TetA(C) is functional with a HixC site in the 1st location (between domains 1&2) and the 2nd location (between domains 9&10). Mouse-over constructs to see HixC sequence and insertion locations.
Construct with 2 HixC sites
Results
E.coli colonies transformed with a Tet construct formed a lawn of small colonies (plate on right) rather than distinct colonies (plate on left). I hypothesized that this indicated TetA(C) functionality because tet resistance is known to adversely affect cell growth rate, viability, and antibiotic susceptibility. Yet, tet resistance assays revealed that the Tet constructs I built did not express a functional TetA(C) protein.